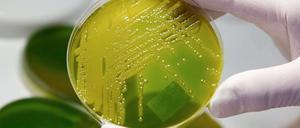

Stiche, Schüsse, Schläge: Gewalt der Hells Angels greift auf den Kiez im Norden Berlins über. Ein Italiener und sein Sohn gerieten Samstag Nacht in das Visier der Hells Angels.
Hannes Heine
Alles Hoffen und Bangen hat nichts genützt: Der misshandelte Säugling aus Pankow ist tot. Dringend tatverdächtig ist der Vater. Der schweigt bisher.
Zehn Fälle sind in Berlin seit Beginn der Meldepflicht im Juli 2011 angezeigt worden. Darunter war auch der Erreger, an dem Säuglinge in Bremen starben.

Der Ton wird schärfer: Gewerkschaften und Opposition warnen vor der Ausgliederung von Polizeiaufgaben an private Sicherheitsfirmen. Hintergrund sind erhoffte Kosteneinsparungen. Aber was zählt zu den Kernaufgaben des Staates?
Der Vorstand der Kassenärztlichen Vereinigung (KV) hat Klage gegen den Berliner Senat eingereicht. Gesundheitssenator Mario Czaja (CDU) hatte im Februar einen Bescheid erlassen, wonach der dreiköpfige Vorstand verpflichtet wird, erhaltene Bonusgelder an die KV zurückzuzahlen.
Hunderte Menschen bekundeten vor dem Rathaus Neukölln ihr Mitgefühl für den getöteten Jusef El-A. Trotz der Angst, dass sich radikale Muslime oder gewaltbereite Jugendliche unter die Menge mischen könnten, blieb alles ruhig.

500 Euro im Monat zahlt der britische Musiker an die Berliner Justizkasse – das wird sich wahrscheinlich bis Ende 2016 hinziehen

500 Euro im Monat zahlt der britische Musiker an die Berliner Landeskasse – wahrscheinlich bis 2016. Er hatte 2009 ein Auto in Kreuzberg demoliert.

Laut einer Studie der DAK fehlen Berliner am Arbeitsplatz besonders oft – überdurchschnittlich stark betroffen ist der öffentliche Dienst.
Möglicherweise sind auch an der Charité medizinische Leistungen falsch abgerechnet worden. Der Abschlussbericht einer Wirtschaftsprüfungsgesellschaft soll demnächst vorliegen.
Gewerkschafter planen erneut Aktionen in den Kliniken. BSR war komplett lahmgelegt.

Für Donnerstag hat Verdi zu weiteren Aktionen in Berliner Kliniken und der Potsdamer Verwaltung aufgerufen. Am Mittwoch war der Betrieb bei der BSR lahmgelegt. In anderen Bereichen waren die Folgen nicht so zu spüren.

Die Dienstleistungsgewerkschaft Verdi ruft in Berlin für Mittwoch zu ganztägigen Aktionen auf. Brandenburg ist einen Tag später dran. Der Schwerpunkt liegt in Potsdam.
auch bei der BSR.

Neben OP-Schwestern in Vivantes-Kliniken könnten schon am Mittwoch auch Beschäftigte der Stadtreinigung die Arbeit niederlegen.

Rund 100 Polizisten sollen beim Objektschutz und in den Gefangenensammelstellen sowie 340 Frauen und Männer in der Justiz eingespart werden. Die angekündigten 250 Zusatzkräfte sind wohl erst 2015 komplett einsatzfähig - das stört vor allem die Grünen.
Dem früheren Kopf der Neuruppiner XY-Bande, Olaf K., droht eine neue Anklage. Er soll in der Haft eine neue Straftat geplant haben.

Am Mittwoch gab es mehrere Verletzte, als ein Radfahrer am Anhalter Bahnhof die Spur eines BVG-Doppeldeckers schnitt. Der Bus bremste, Fahrgäste stürzten. Dem Radler passierte nichts, er dürfte aber Probleme bekommen.
Dem früheren Kopf der Neuruppiner XY-Bande, Olaf K., droht eine neue Anklage. Er soll hinter Gittern eine Erpressung geplant haben.

Flüge, Finca, Golf: Der Regierende hatte viel zu erklären, als er am Dienstag ins Rote Rathaus kam. Ein entscheidendes Detail aber hätte Klaus Wowereit beinahe vergessen.
Berlin - In Berlin brennt es im Schnitt 22-mal am Tag, in den meisten Fällen geht es glimpflich aus. Vor einem Jahr konnte selbst der Einsatz einer Feuerwehr-Hundertschaft drei Menschen aus dem Haus Sonnenallee 18 nicht mehr retten.
Kein Hinweis auf Täter.
Während in anderen Bundesländern die Warnstreiks heute weitergehen, ist die Gefahr weiterer Ausstände auf Berlins Flughäfen vorerst gebannt. Kurz vor Torschluss hat Bodendienstleister Globeground ein Angebot vorgelegt.
An den Berliner Flughäfen Tegel und Schönefeld wird es an diesem Freitag keine Warnstreiks geben. Das sagte der Verdi-Tarifexperte Jens Gröger am Donnerstagabend der Nachrichtenagentur dpa in Berlin.